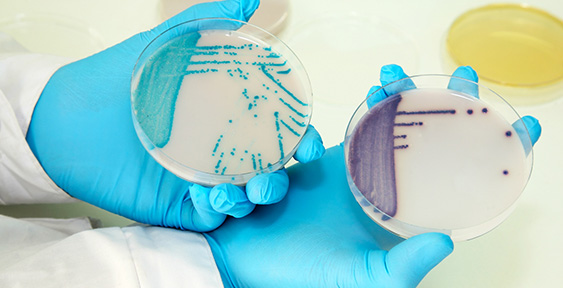

- Cursos
- Certificaciones
- Consultoría
- Sectores
- Programas de intercomparación
-
Cursos
- Metrologia y Calibración
- Incertidumbre
- Prácticos de Medición y Calibración
- Validar y controlar medidas y ensayos
- Normativas y Auditorías
- Calidad Industrial - Core Tools
- Estadística en industria y laboratorios
- Metrología Legal
- LEAN / Mejora Continua
- Certificaciones
- Consultoría
- Sectores
- Programas de intercomparación